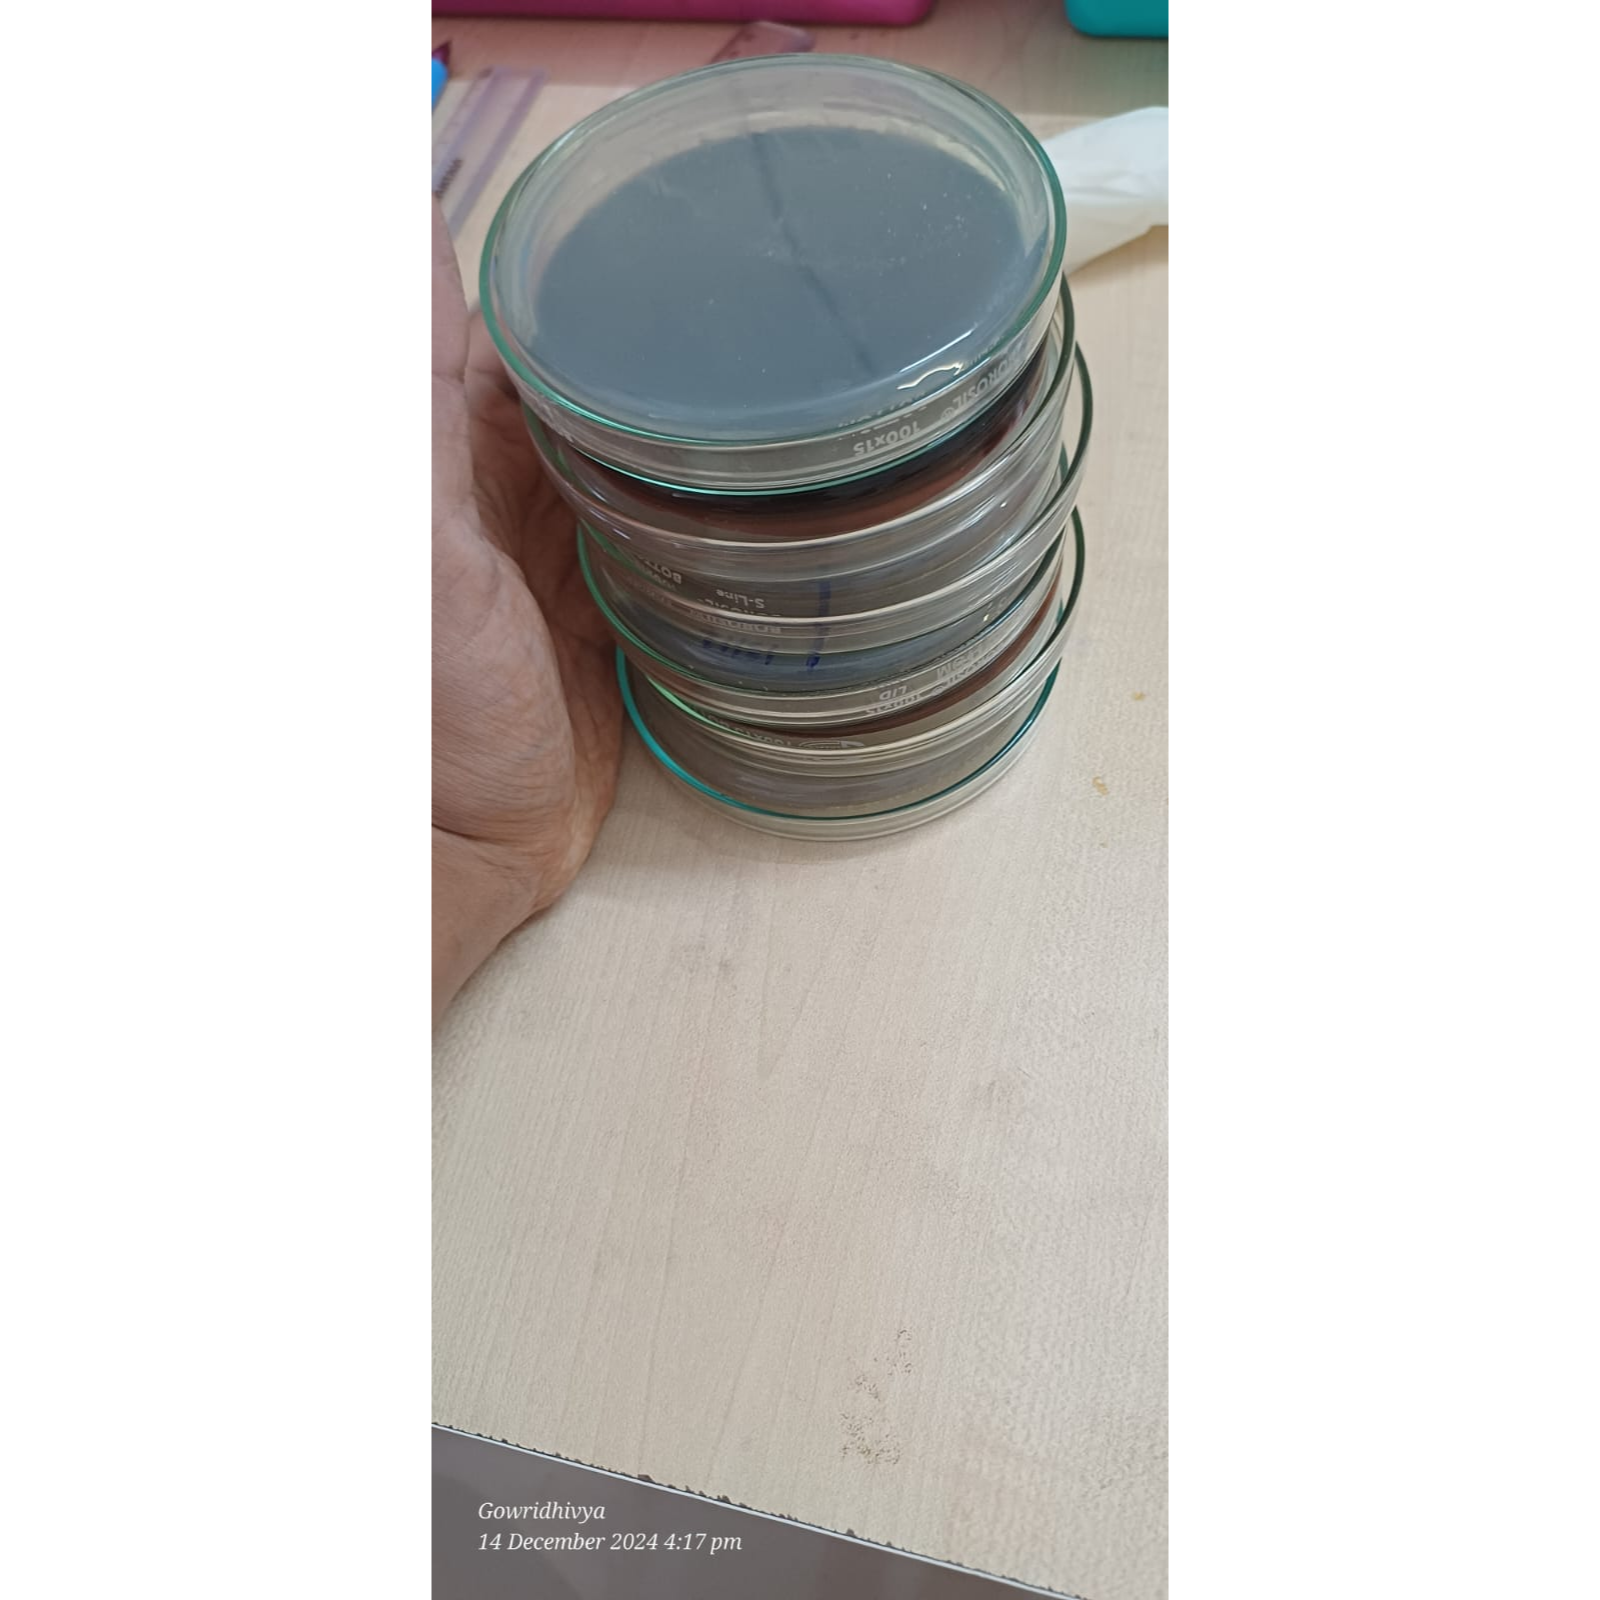

Synthesis Lab Technology is and FSSAI-approved food testing lab based in COIMBATORE. We provide accurate, affordable, and timely testing for packaged food, beverages, water, dairy, and agricultural products. Our services cover microbiological analysis, shelf-life studies, nutritional labeling, and more. Trusted by leading food businesses for compliance and safety.
Submit Your Enquiry